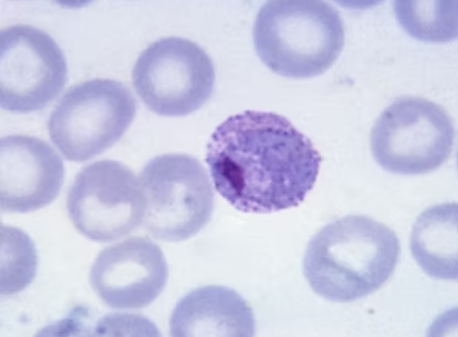

Hemograma na malária
A malária é uma doença infecciosa causada por protozoários do gênero Plasmodium, com destaque para o Plasmodium falciparum, espécie associada a maior gravidade clínica e letalidade. Após a inoculação pelo mosquito Anopheles, o parasita passa pelas fases hepática e eritrocitária, desencadeando alterações sistêmicas importantes. Nesse contexto, o hemograma assume papel central, uma vez que reflete tanto a resposta do hospedeiro quanto a intensidade da infecção.
Além disso, o hemograma auxilia no diagnóstico diferencial, permitindo avaliar a gravidade da doença e acompanhar a evolução clínica do paciente. As alterações observadas nos eritrócitos, leucócitos e plaquetas são frequentes e variam conforme a espécie do parasita, a carga parasitária e as condições clínicas associadas.
Alterações eritrocitárias na malária
Entre as alterações hematológicas, a anemia é uma das mais comuns na malária, sendo geralmente normocítica e normocrômica nos quadros não complicados. Ela se estabelece, refletindo a destruição tanto de hemácias infectadas quanto não infectadas.
Esse quadro, por sua vez, resulta de múltiplos mecanismos, como a hemólise intravascular, a eritrofagocitose e a possível inibição da eritropoiese. Além disso, fatores relacionados ao hospedeiro, condições nutricionais e a coexistência de parasitoses intestinais podem agravar a anemia observada durante a infecção malárica.
Leucograma na infecção malárica
As alterações leucocitárias na malária são variáveis e dependem do estágio da doença e do momento da coleta. Em muitos pacientes, o número total de leucócitos permanece dentro da normalidade, entretanto, podem ocorrer leucopenia ou leucocitose, especialmente em quadros mais graves. No leucograma diferencial, a linfopenia é frequentemente descrita durante a fase aguda da infecção, estando relacionada à resposta inflamatória sistêmica e à redistribuição celular.

Plaquetograma na malária
A trombocitopenia é um achado frequente tanto na malária por P. falciparum quanto por P. vivax. De modo geral, a redução do número de plaquetas ocorre sem sangramentos clinicamente significativos, porém, pode estar associada à gravidade do quadro infeccioso.
Entre os mecanismos propostos, destacam-se a destruição plaquetária mediada por imunocomplexos, a ativação plaquetária e a hiperatividade do baço, que promove maior fagocitose. Apesar disso, a recuperação plaquetária costuma ser rápida após o tratamento antimalárico adequado.
Conclusão
O hemograma, quando associado à lâmina de sangue periférico, é uma ferramenta essencial no manejo da malária. Dessa forma, ele permite identificar alterações precoces, monitorar a resposta ao tratamento e reconhecer possíveis complicações hematológicas ao longo da evolução da doença.
Na malária, o hemograma reflete de forma direta o impacto do parasita sobre o sistema hematológico. Assim, anemia e trombocitopenia destacam-se como as alterações mais frequentes, enquanto as mudanças no leucograma variam conforme a fase da infecção e o tratamento instituído. Portanto, o hemograma não apenas auxilia no diagnóstico, mas também no monitoramento clínico e na avaliação da gravidade, sendo indispensável na prática laboratorial e clínica diante da malária.
O próximo passo de todo analista que deseja ter mais segurança na bancada
Todo analista que busca se destacar e se tornar um profissional mais atualizado, capacitado e qualificado para o mercado de trabalho precisa considerar uma pós-graduação.
Um profissional com especialização é valorizado na área laboratorial; esse é um fato inegável.
Unimos o útil ao agradável ao desenvolver uma pós-graduação em Hematologia Laboratorial e Clínica.
Para aqueles que procuram a comodidade de uma pós-graduação 100% online e ao vivo, sem abrir mão da excelência no ensino, temos a solução ideal.
Nossa metodologia combina teoria e prática da rotina laboratorial, garantindo um aprendizado efetivo.
Contamos com um corpo docente altamente qualificado, com os melhores professores do Brasil, referências em suas áreas de atuação.
No Instituto Nacional de Medicina Laboratorial, temos apenas um objetivo: mais do que ensinar, vamos tornar VOCÊ uma referência.
Toque no botão abaixo e conheça a pós-graduação em Hematologia Laboratorial e Clínica.
QUERO CONHECER TODOS OS DETALHES DA PÓS-GRADUAÇÃO
Referências:
COSTA, Anielle de Pina; BRESSAN, Clarisse da Silveira; PEDRO, Renata Saraiva; VALLS-DE-SOUZA, Rogério; SILVA, Sidnei da; SOUZA, Patrícia Rosana de; GUARALDO, Lusiele; FERREIRA-DA-CRUZ, Maria de Fátima; DANIEL-RIBEIRO, Cláudio Tadeu; BRASIL, Patrícia. Diagnóstico tardio de malária em área endêmica de dengue na extra-Amazônia brasileira: experiência recente de uma unidade sentinela no Estado do Rio de Janeiro. Revista da Sociedade Brasileira de Medicina Tropical, v. 43, n. 5, p. 571-574, set./out. 2010.
DONGUA, Kule Kunga Alicerces Moisés; LUÍS, Mariele Santa Rita da Silva. Alterações hematológicas em pacientes com malária por Plasmodium falciparum atendidos no Hospital Municipal de Benguela. RevSALUS – Revista Científica Internacional da RACS, v. 7, n. Suppl. II, 2025. Suplemento. DOI: 10.51126/y945k317.
PINEDO-CANCINO, Viviana; ARISTA, Katty M.; VALLE-CAMPOS, Andree; SAAVEDRA-LANGER, Rafael; ROCA, Cristian; RAMOS-RINCÓN, José-Manuel; CALDERÓN, Maritza; BRANCH, Oralee H. Perfiles hematológicos en pacientes infectados con malaria en un área endémica del Perú. Revista Peruana de Medicina Experimental y Salud Pública, v. 39, n. 3, p. , jul./set. 2022. DOI: 10.17843/rpmesp.2022.393.11908.CARMONA-FONSECA, Jaime. Evolución temporal del hemograma en niños con malaria. Iatreia, v. 21, n. 3, set. 2008.



